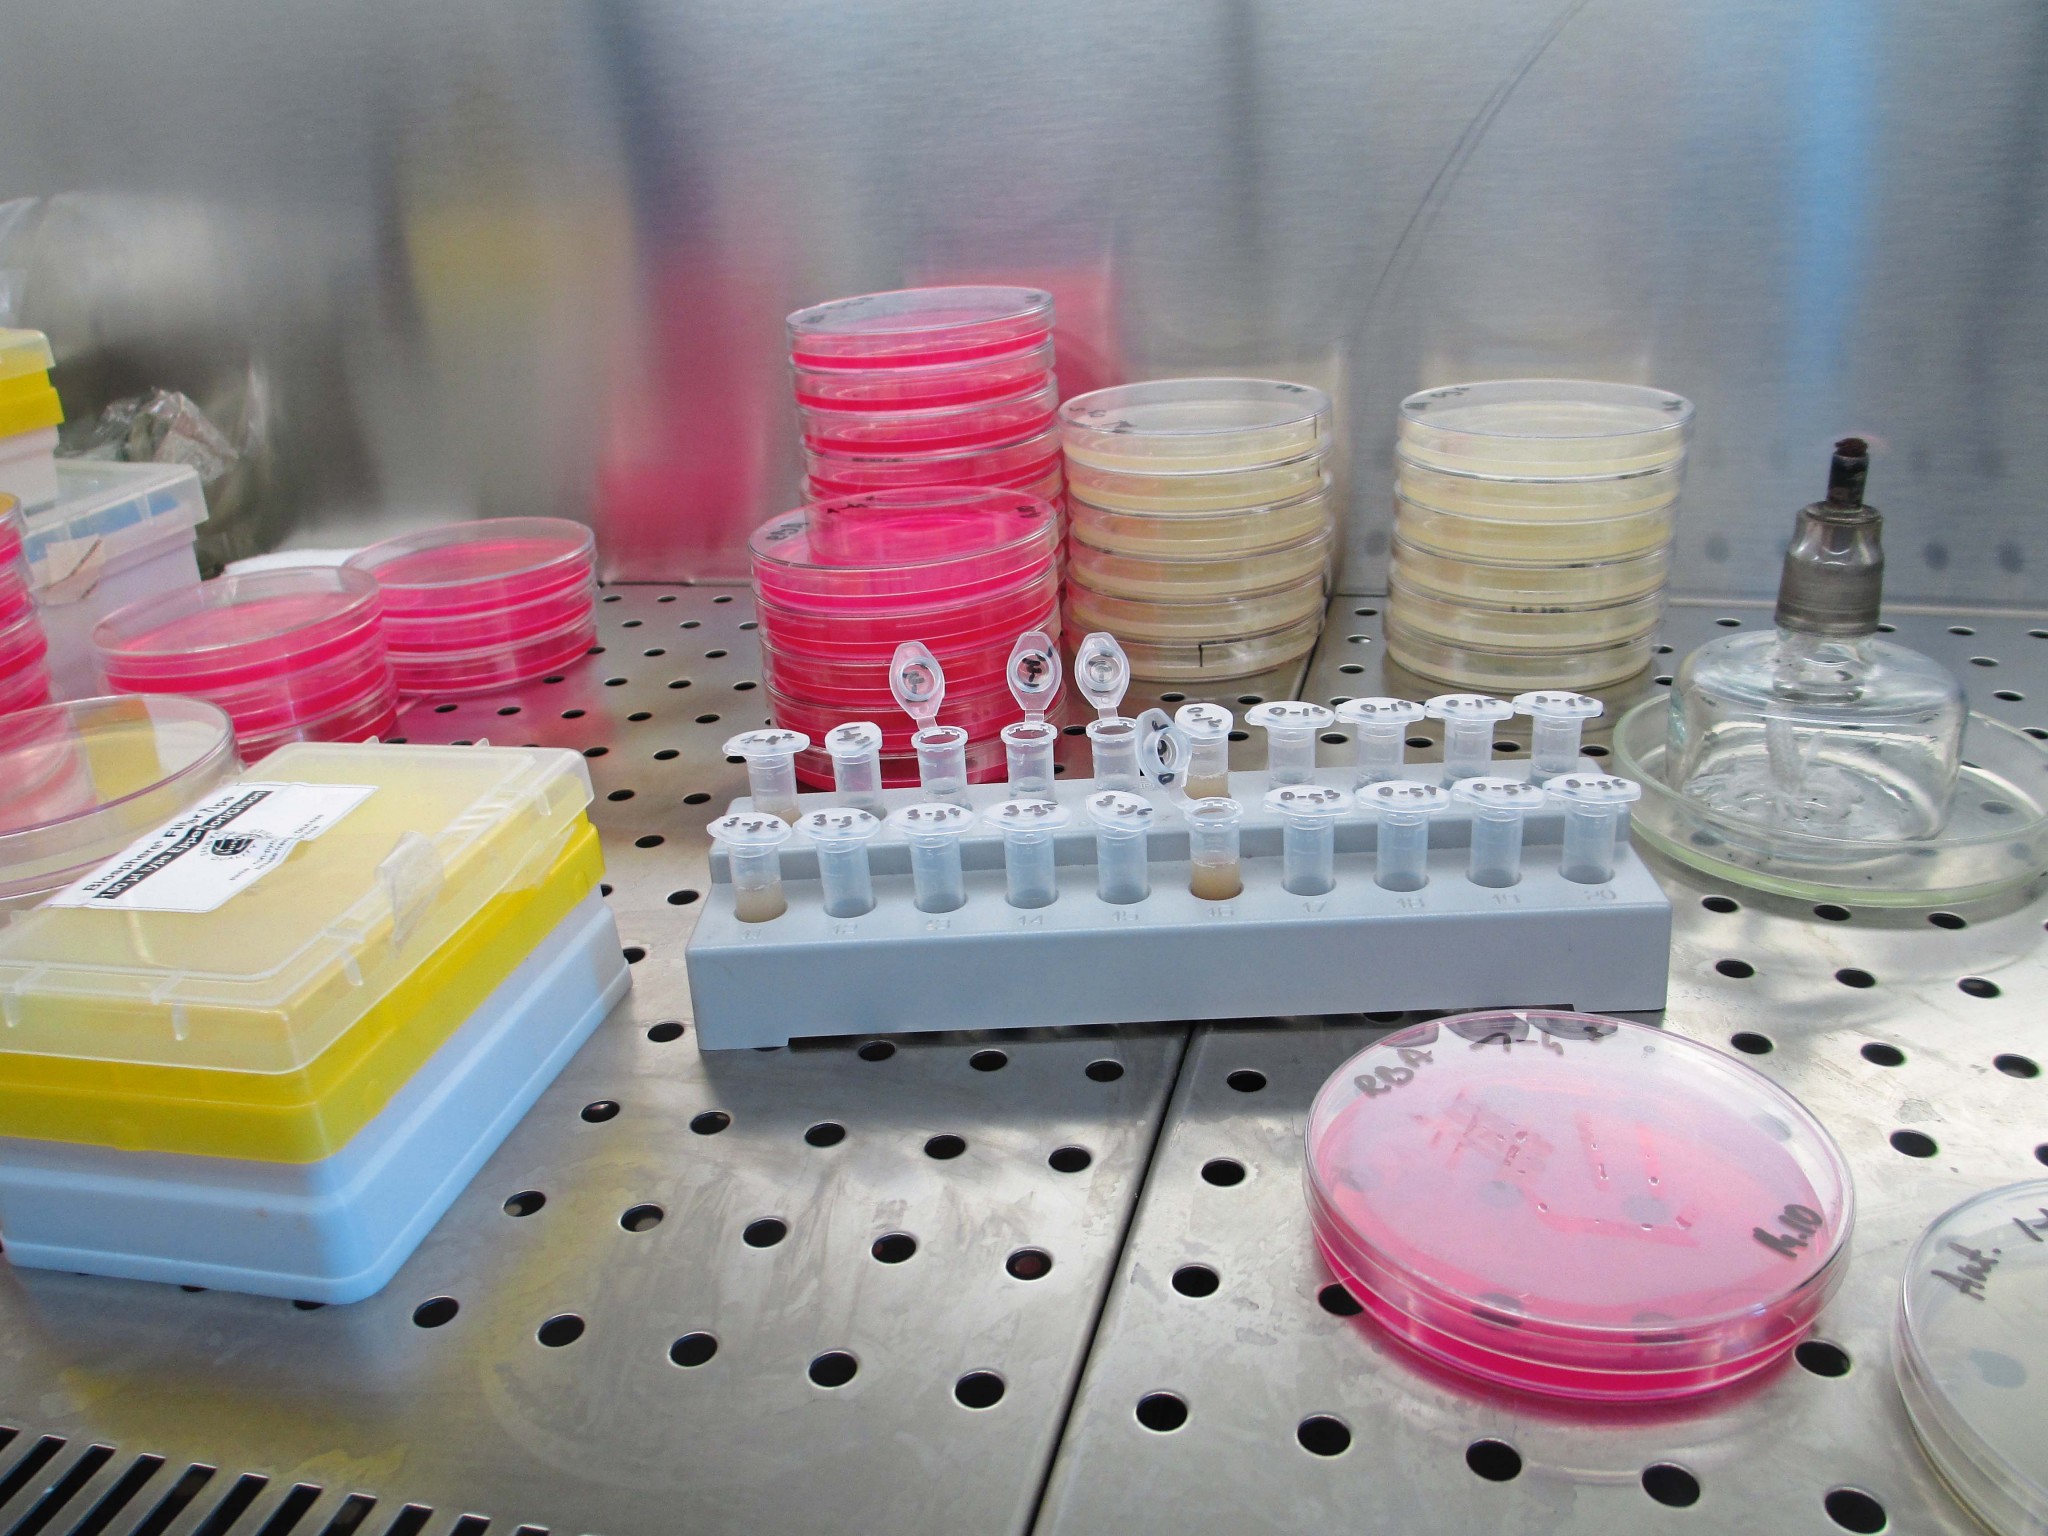

Медицина 4.0: данные важнее человека
Цифровая медицина обещает найти решения для любых проблем. Но к нашей доверчивости технологиям добавляется неприятное ощущение: она сосредоточена не на человеке, а на его данных.

В 1978 году появился на свет не только первый выпуск CHIP, но и Луиз Джой Браун, более известная как первый ребенок «из пробирки». Звучит весьма стерильно. Медицина и компьютеры в то время были разными вселенными. Прогрессивные исследователи-медики проводили в основном биохимические эксперименты, интегральные схемы интересовали исключительно ботаников и Стива Джобса.
Сегодня же уже школьники начальных классов считают занудами своих ровесников, которые ведут активный образ жизни без смартфонов и социальных сетей. Совершенно невообразимы медицинские исследования без цифровой поддержки. Конечно, по сути, это относится ко всем областям знаний, но перспективы цифровой революции кажутся особенно привлекательными, когда речь заходит о здравоохранении. Из-за экспоненциального развития технологии производства процессоров и памяти, а также объемов данных, которые могут быть использованы, в обозримом будущем намечаются значительные подвижки в исследовании многих медицинских проблем.
Большие надежды врачи возлагают на машинное обучение; так, платформа ИИ Watson разработки IBM уже оправдывает многие ожидания в области лечения рака. Благодаря использованию больших данных и возможностей искусственного интеллекта Watson превращается в сверхученого, который все понимает, очень быстро учится и предлагает обоснованные решения. Может быть, «Шерлок Холмс» было бы более удачным названием для ИИ, но Watson — это не отсылка к верному спутнику великого сыщика Ватсону, а фамилия бывшего руководителя IBM — его звали Томас Уотсон. Могущество ИИ Watson — обработка данных любых видов. Его понимание семантических отношений лучше, чем у человека. Он превосходно справляется с неструктурированными данными, которые не подчиняются математическому или информационному упорядочению, — речью, текстами, видео, аудиоданными, записями от руки и даже публикациями в соцсетях. Такое тонкое умение работать с большими данными IBM использует вместе с организацией Quest Diagnostics, предлагающей лабораторно-диагностические услуги, для проведения терапии для онкобольных с применением решения Watson for Genomics.

Лечение онкологии очень сильно зависит от правильного сочетания правильных сведений. Так, три четверти всех пациентов реагируют не на все лекарства на одинаково действующем веществе. Кроме того, большинство онкологов занимаются пациентами с различными видами онкологических заболеваний. Но ведь каждый пациент отличается от других, и мутации тоже не похожи друг на друга. Совершенно исключено, чтобы лечащий онколог был знаком со всеми актуальными методами диагностики и лечения для каждого отдельного случая: по данным IBM, из года в год публикуется около 160 000 исследований в области онкологии, поэтому вероятность того, что онкобольной получит оптимальное лечение, включая соответствующие лекарства, чрезвычайно мала.
Watson обучается на образах, которые распознает в больших данных
И тут в игру вступает геномика. Программа Watson обнаруживает корреляции в огромных массивах данных и может на основе постоянных анализов обучаться, устранять ошибки и улучшать собственную работу. Перед тем как задействовать Watson, лаборатория Quest Diagnostics берет образец ткани для исследования генома опухоли. Затем данные о последовательности ДНК лаборатория отправляет искусственному интеллекту Watson. Машина штудирует миллионы страниц специальной литературы, исследований и прочей имеющей большое значение информации, чтобы в итоге создать подробный отчет с описанием изменений ДНК и вариантами терапии с учетом этих мутаций. На его основе онколог составляет план лечения пациента. Так большие данные и ИИ помогают проводить индивидуальную терапию с применением самых современных методов.
Михаэль Буркхарт, руководитель отдела здравоохранения и фармацевтики компании PwC, предоставляющей услуги в области бизнес-консультирования, ожидает, что применение тщательно подобранных данных в медицине коренным образом изменит сектор здравоохранения: «Я убежден, что такие технологии, как искусственный интеллект и большие данные, произведут переворот в нашей системе здравоохранения». Отдельно взятому пациенту это в итоге пойдет на пользу, как говорит эксперт в беседе с CHIP: «Самые большие возможности искусственного интеллекта и больших данных, кроме более точной диагностики, я вижу в персонализации медицины, позволяющей проводить терапию в более индивидуализированной и, следовательно, более целенаправленной форме».
«Мы должны задать себе вопрос, являются ли новые технологии уже в достаточной степени проверенными». Михаэль Буркхарт, руководитель отдела здравоохранения и фармацевтики PwC
Медицинские исследования с использованием машинного обучения находятся только на заре своего развития, и по-прежнему существуют огромные проблемы датафикации, преобразования информации в нужные форматы данных. Миграция данных из устаревших систем на новые платформы тоже оказывается непростой задачей. Даже сбор цифровых данных в приемном отделении еще далеко не обыденное занятие, так что информационно-цифровой поток между отделениями одной и той же больницы затруднен, а препятствия в обмене данными между двумя разными клиниками еще более серьезны.